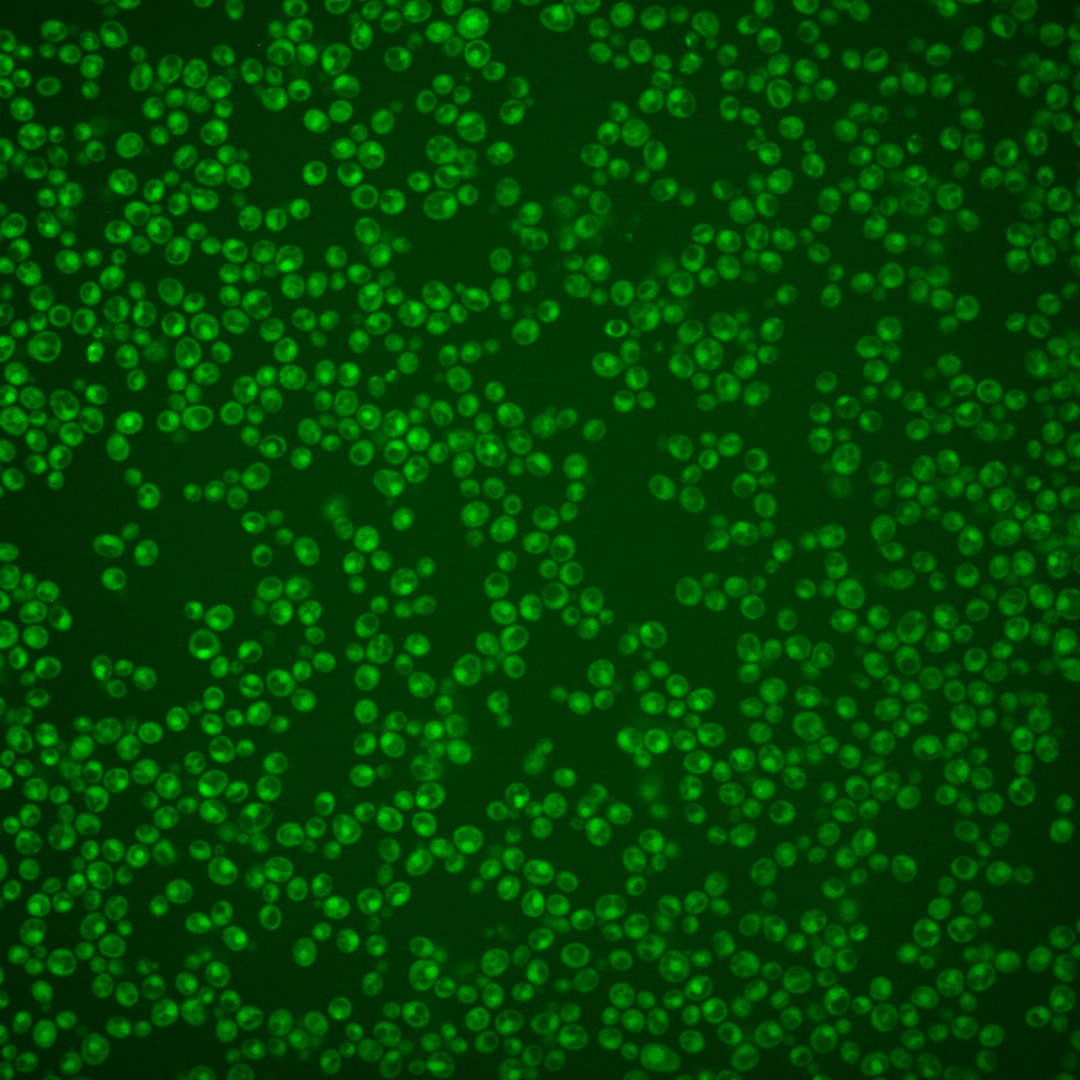
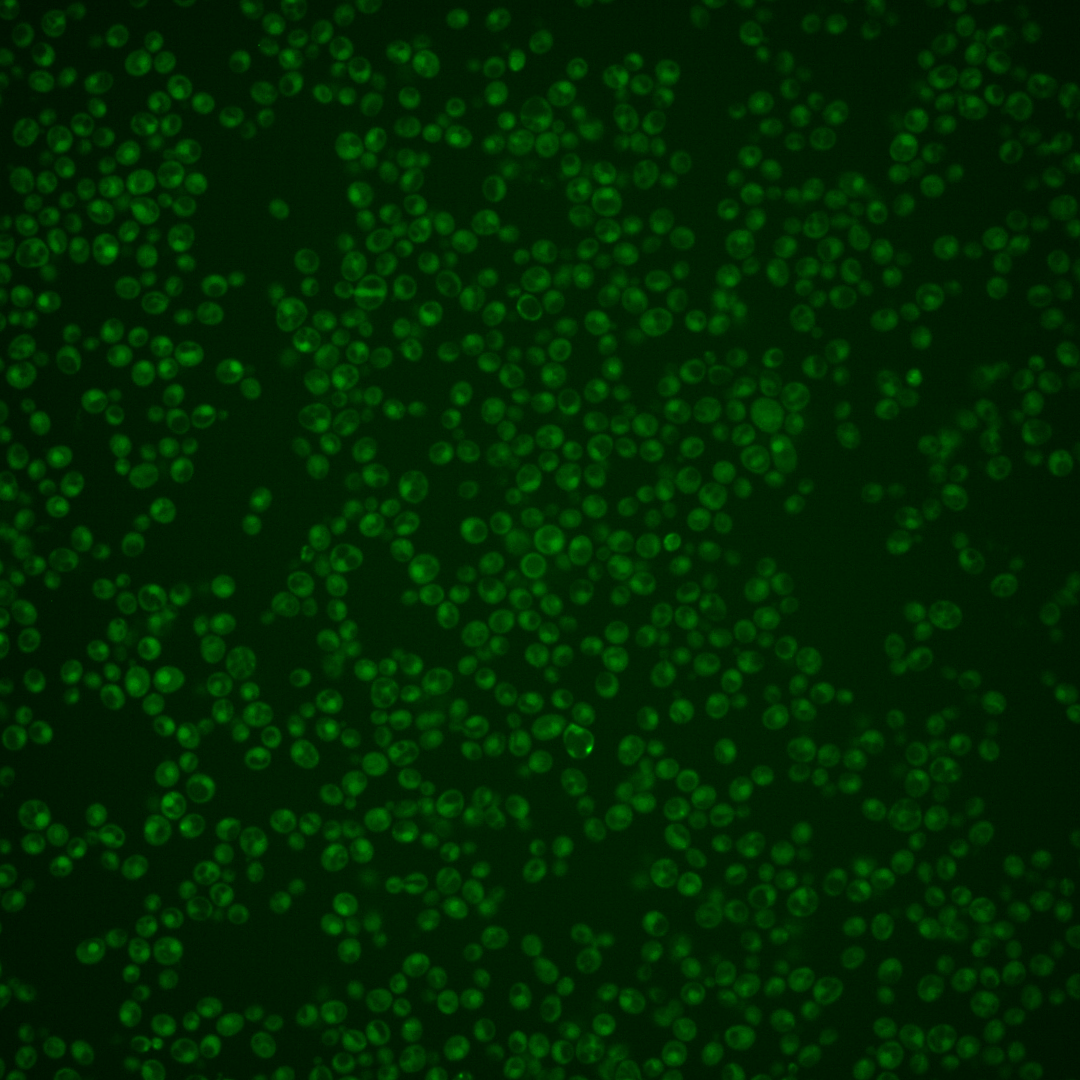
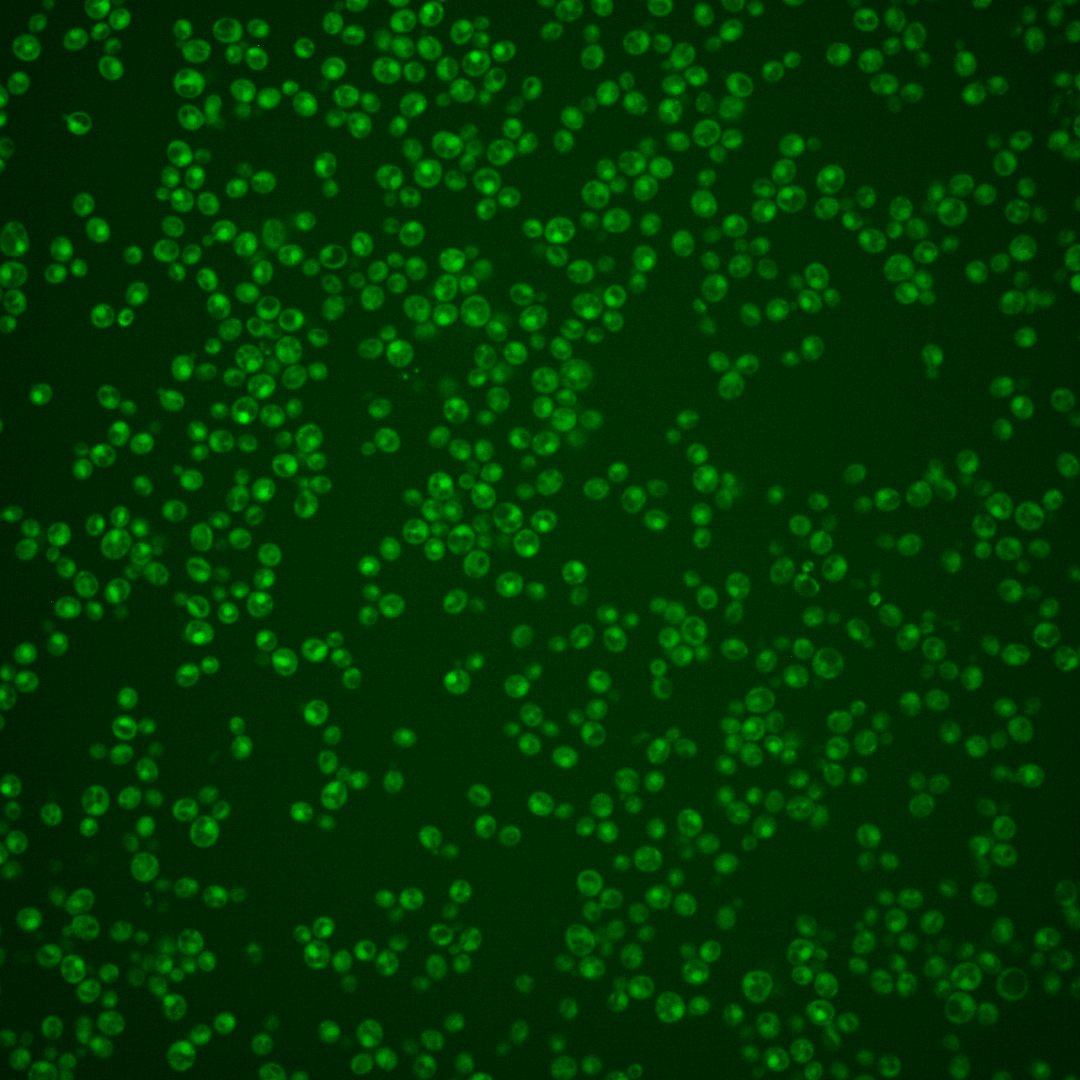

| Standard name | |
|---|---|
| Human Ortholog | |
| Description | DNA replication initiation protein; loads DNA pol epsilon onto pre-replication complexes at origins; checkpoint sensor recruited to stalled replication forks by the checkpoint clamp complex where it activates Mec1p; along with Rfa1p, binds to ultrafine anaphase bridges in mitotic cells and prevents accumulation of chromatin bridges by stimulating the Mec1p kinase and suppressing homologous recombination; ortholog of human TopBP1; forms nuclear foci upon DNA replication stress |
Micrographs




















































































Sub-cellular Localization
Yeast GFP Assignment
Protein Abundance
Localization Change
External localization resources
| ensLOC | DeepLoc | |||||||||||||||||||||||
|---|---|---|---|---|---|---|---|---|---|---|---|---|---|---|---|---|---|---|---|---|---|---|---|---|
| Localization | WT1 | WT2 | WT3 | RAP60 | RAP140 | RAP220 | RAP300 | RAP380 | RAP460 | RAP540 | RAP620 | RAP700 | HU80 | HU120 | HU160 | rpd3Δ_1 | rpd3Δ_2 | rpd3Δ_3 | WT1 | WT2 | WT3 | AF100 | AF140 | AF180 |
| Cortical Patches | 0 | 1 | 0 | 0 | 0 | 0 | 0 | 0 | 0 | 0 | 0 | 0 | 0 | 0 | 0 | 0 | 0 | 0 | 0 | 1 | 0 | 0 | 3 | 3 |
| Bud | 2 | 1 | 0 | 1 | 1 | 1 | 3 | 0 | 9 | 3 | 6 | 6 | 1 | 0 | 0 | 0 | 0 | 0 | 1 | 3 | 2 | 6 | 9 | 6 |
| Bud Neck | 1 | 1 | 10 | 6 | 6 | 1 | 8 | 14 | 5 | 1 | 3 | 12 | 0 | 0 | 0 | 0 | 0 | 0 | 0 | 3 | 3 | 0 | 3 | 5 |
| Bud Site | 0 | 1 | 0 | 0 | 0 | 1 | 7 | 1 | 6 | 7 | 8 | 9 | 0 | 0 | 0 | 0 | 0 | 0 | – | – | – | – | – | – |
| Cell Periphery | 0 | 0 | 2 | 0 | 0 | 0 | 0 | 2 | 0 | 0 | 0 | 0 | 0 | 0 | 0 | 2 | 2 | 0 | 0 | 0 | 0 | 0 | 0 | 1 |
| Cytoplasm | 46 | 82 | 101 | 52 | 70 | 160 | 133 | 121 | 102 | 100 | 64 | 61 | 72 | 82 | 98 | 164 | 151 | 130 | 44 | 55 | 68 | 39 | 98 | 133 |
| Endoplasmic Reticulum | 2 | 0 | 0 | 0 | 0 | 0 | 0 | 0 | 0 | 0 | 1 | 0 | 1 | 0 | 3 | 12 | 8 | 4 | 1 | 0 | 1 | 0 | 3 | 5 |
| Endosome | 0 | 1 | 0 | 0 | 1 | 0 | 0 | 0 | 0 | 0 | 0 | 0 | 2 | 21 | 3 | 8 | 10 | 2 | 0 | 5 | 0 | 1 | 1 | 4 |
| Golgi | 0 | 1 | 0 | 0 | 0 | 0 | 0 | 0 | 0 | 0 | 0 | 0 | 0 | 0 | 0 | 0 | 0 | 1 | 1 | 2 | 0 | 0 | 1 | 0 |
| Mitochondria | 35 | 42 | 9 | 31 | 22 | 87 | 112 | 71 | 190 | 211 | 180 | 148 | 47 | 12 | 36 | 8 | 5 | 2 | 11 | 7 | 12 | 14 | 24 | 30 |
| Nucleus | 40 | 57 | 65 | 52 | 36 | 61 | 64 | 64 | 60 | 91 | 78 | 82 | 88 | 53 | 69 | 18 | 14 | 28 | 60 | 94 | 73 | 26 | 17 | 9 |
| Nuclear Periphery | 0 | 0 | 0 | 0 | 0 | 0 | 0 | 1 | 1 | 3 | 1 | 1 | 0 | 0 | 0 | 1 | 0 | 0 | 0 | 0 | 0 | 0 | 0 | 1 |
| Nucleolus | 0 | 0 | 0 | 0 | 0 | 0 | 0 | 0 | 1 | 0 | 0 | 0 | 2 | 4 | 0 | 0 | 1 | 1 | 0 | 0 | 0 | 0 | 1 | 0 |
| Peroxisomes | 0 | 0 | 0 | 0 | 0 | 0 | 0 | 0 | 0 | 0 | 0 | 0 | 0 | 1 | 0 | 0 | 0 | 0 | 0 | 0 | 0 | 0 | 0 | 0 |
| SpindlePole | 0 | 4 | 0 | 2 | 1 | 5 | 5 | 4 | 2 | 2 | 2 | 3 | 1 | 0 | 0 | 0 | 0 | 0 | 7 | 14 | 5 | 2 | 5 | 9 |
| Vac/Vac Membrane | 35 | 53 | 11 | 4 | 13 | 17 | 8 | 16 | 6 | 11 | 8 | 4 | 56 | 63 | 55 | 108 | 101 | 54 | 50 | 80 | 84 | 61 | 106 | 80 |
| Unique Cell Count | 138 | 206 | 189 | 130 | 137 | 299 | 266 | 257 | 285 | 328 | 254 | 244 | 235 | 214 | 230 | 262 | 246 | 196 | 185 | 277 | 269 | 162 | 281 | 301 |
| Labelled Cell Count | 161 | 244 | 198 | 148 | 150 | 333 | 340 | 294 | 382 | 429 | 351 | 326 | 270 | 236 | 264 | 321 | 292 | 222 | 185 | 277 | 269 | 162 | 281 | 301 |
Yeast GFP Assignment
Protein Abundance
| Screen | WT1 | WT2 | WT3 | RAP60 | RAP140 | RAP220 | RAP300 | RAP380 | RAP460 | RAP540 | RAP620 | RAP700 | HU80 | HU120 | HU160 | rpd3Δ_1 | rpd3Δ_2 | rpd3Δ_3 | AF100 | AF140 | AF180 |
|---|---|---|---|---|---|---|---|---|---|---|---|---|---|---|---|---|---|---|---|---|---|
| Mean Cell GFP Intensity (1e-4) | 4.0 | 4.0 | 4.6 | 4.2 | 4.8 | 3.8 | 3.8 | 4.2 | 3.3 | 3.3 | 3.1 | 3.6 | 4.5 | 4.5 | 4.1 | 7.0 | 7.7 | 6.8 | 4.2 | 4.1 | 4.6 |
| Std Deviation (1e-4) | 0.7 | 0.8 | 1.0 | 1.2 | 1.4 | 1.3 | 1.2 | 1.4 | 0.8 | 1.1 | 0.9 | 0.9 | 1.5 | 1.3 | 1.3 | 1.5 | 2.0 | 1.7 | 1.8 | 1.6 | 1.9 |
| Intensity Change (Log2) | – | – | – | -0.13 | 0.06 | -0.26 | -0.25 | -0.14 | -0.48 | -0.48 | -0.54 | -0.36 | -0.03 | -0.02 | -0.14 | 0.62 | 0.76 | 0.58 | -0.11 | -0.15 | 0.0 |
Localization Change
| Localization | RAP60 | RAP140 | RAP220 | RAP300 | RAP380 | RAP460 | RAP540 | RAP620 | RAP700 | HU80 | HU120 | HU160 | rpd3Δ_1 | rpd3Δ_2 | rpd3Δ_3 |
|---|---|---|---|---|---|---|---|---|---|---|---|---|---|---|---|
| Actin | – | – | – | – | – | – | – | – | – | – | – | – | – | – | – |
| Bud | – | – | – | – | – | – | – | – | – | – | – | – | 0 | 0 | 0 |
| Bud Neck | – | – | – | – | – | – | – | – | – | – | – | – | 0 | 0 | 0 |
| Bud Site | – | – | – | – | – | – | – | – | – | – | – | – | 0 | 0 | 0 |
| Cell Periphery | – | – | – | – | – | – | – | – | – | – | – | – | 0 | 0 | 0 |
| Cyto | – | – | – | – | – | – | – | – | – | – | – | – | – | – | – |
| Endoplasmic Reticulum | – | – | – | – | – | – | – | – | – | – | – | – | 0 | 0 | 0 |
| Endosome | – | – | – | – | – | – | – | – | – | – | – | – | 0 | 0 | 0 |
| Golgi | – | – | – | – | – | – | – | – | – | – | – | – | 0 | 0 | 0 |
| Mitochondria | – | – | – | – | – | – | – | – | – | – | – | – | 0 | 0 | 0 |
| Nuclear Periphery | – | – | – | – | – | – | – | – | – | – | – | – | 0 | 0 | 0 |
| Nuc | – | – | – | – | – | – | – | – | – | – | – | – | – | – | – |
| Nucleolus | – | – | – | – | – | – | – | – | – | – | – | – | 0 | 0 | 0 |
| Peroxisomes | – | – | – | – | – | – | – | – | – | – | – | – | 0 | 0 | 0 |
| SpindlePole | – | – | – | – | – | – | – | – | – | – | – | – | 0 | 0 | 0 |
| Vac | – | – | – | – | – | – | – | – | – | – | – | – | – | – | – |
| Cortical Patches | – | – | – | – | – | – | – | – | – | – | – | – | 0 | 0 | 0 |
| Cytoplasm | – | – | – | – | – | – | – | – | – | – | – | – | 0 | 0 | 0 |
| Nucleus | – | – | – | – | – | – | – | – | – | – | – | – | 0 | 0 | 0 |
| Vacuole | – | – | – | – | – | – | – | – | – | – | – | – | 8.4 | 8.3 | 5.7 |
External localization resources
Images






























Protein Concentration and Protein Localization Data
| R1 | R2 | R3 | ||||||||||||||||
|---|---|---|---|---|---|---|---|---|---|---|---|---|---|---|---|---|---|---|
| G1 Pre-START | G1 Post-START | S/G2 | Metaphase | Anaphase | Telophase | G1 Pre-START | G1 Post-START | S/G2 | Metaphase | Anaphase | Telophase | G1 Pre-START | G1 Post-START | S/G2 | Metaphase | Anaphase | Telophase | |
| Concentration | -0.6069 | -0.6193 | -0.5326 | -1.2208 | -0.7732 | -0.8288 | 0.0297 | 0.1845 | 0.2518 | -0.3198 | -0.2554 | 0.1699 | -0.9014 | -0.1766 | -0.6635 | -0.3951 | -0.6146 | -0.6176 |
| Actin | 0.0653 | 0.0008 | 0.0101 | 0.0006 | 0.0006 | 0.0123 | 0.0262 | 0.0004 | 0.0101 | 0.0377 | 0.0006 | 0.0171 | 0.0003 | 0.0043 | 0.001 | 0.0003 | 0.0004 | 0.0004 |
| Bud | 0.0012 | 0.0004 | 0.0009 | 0.0001 | 0 | 0.0014 | 0.001 | 0.0002 | 0.0003 | 0.0004 | 0.0006 | 0.0002 | 0.0001 | 0.0001 | 0.0005 | 0 | 0 | 0.0001 |
| Bud Neck | 0.0024 | 0.0008 | 0.005 | 0.0002 | 0.0006 | 0.0066 | 0.0033 | 0.0022 | 0.0015 | 0.0011 | 0.0032 | 0.005 | 0.0004 | 0.0003 | 0.0007 | 0.0005 | 0.0007 | 0.0033 |
| Bud Periphery | 0.0016 | 0.0005 | 0.0013 | 0.0001 | 0 | 0.0018 | 0.002 | 0.0002 | 0.0003 | 0.0004 | 0.0008 | 0.0003 | 0.0001 | 0.0001 | 0.0005 | 0 | 0 | 0.0001 |
| Bud Site | 0.0102 | 0.003 | 0.0041 | 0.0002 | 0.0027 | 0.0006 | 0.0056 | 0.0027 | 0.0088 | 0.0012 | 0.0052 | 0.0004 | 0.0003 | 0.0011 | 0.0028 | 0.0001 | 0.0001 | 0.0005 |
| Cell Periphery | 0.0007 | 0.0002 | 0.0002 | 0 | 0 | 0.0001 | 0.0006 | 0.0001 | 0.0002 | 0 | 0.0001 | 0.0001 | 0 | 0.0001 | 0 | 0 | 0 | 0 |
| Cytoplasm | 0.1494 | 0.255 | 0.1555 | 0.1482 | 0.1564 | 0.1498 | 0.1537 | 0.2616 | 0.1459 | 0.1317 | 0.1354 | 0.1284 | 0.1294 | 0.1169 | 0.0945 | 0.0724 | 0.0997 | 0.097 |
| Cytoplasmic Foci | 0.0336 | 0.0047 | 0.0258 | 0.0084 | 0.1006 | 0.0131 | 0.0277 | 0.0042 | 0.0109 | 0.0054 | 0.0294 | 0.0072 | 0.0069 | 0.0053 | 0.006 | 0.0015 | 0.0117 | 0.0036 |
| Eisosomes | 0.0007 | 0.0001 | 0.0002 | 0.0002 | 0.0001 | 0.0001 | 0.0005 | 0 | 0.0001 | 0.0001 | 0.0001 | 0.0001 | 0.0001 | 0.0001 | 0.0001 | 0.0001 | 0 | 0 |
| Endoplasmic Reticulum | 0.0071 | 0.0094 | 0.0069 | 0.0032 | 0.0453 | 0.0073 | 0.0082 | 0.0088 | 0.0041 | 0.0023 | 0.0019 | 0.002 | 0.0036 | 0.0028 | 0.0027 | 0.0009 | 0.0015 | 0.0014 |
| Endosome | 0.0482 | 0.0063 | 0.0326 | 0.0055 | 0.0042 | 0.0182 | 0.0404 | 0.0042 | 0.0121 | 0.0034 | 0.0622 | 0.0087 | 0.0076 | 0.0041 | 0.0067 | 0.0011 | 0.0037 | 0.0021 |
| Golgi | 0.0299 | 0.0003 | 0.0137 | 0.0007 | 0.0011 | 0.001 | 0.0149 | 0.0001 | 0.0092 | 0.0036 | 0.0319 | 0.0091 | 0.0002 | 0.0009 | 0.0002 | 0 | 0.0001 | 0.0001 |
| Lipid Particles | 0.0299 | 0.001 | 0.0069 | 0.0093 | 0.0102 | 0.0064 | 0.0188 | 0.0006 | 0.0081 | 0.0017 | 0.0291 | 0.0071 | 0.0015 | 0.001 | 0.0011 | 0.0002 | 0.0006 | 0.0003 |
| Mitochondria | 0.027 | 0.0056 | 0.0098 | 0.1042 | 0.0003 | 0.0048 | 0.0073 | 0.0006 | 0.0037 | 0.0015 | 0.0054 | 0.011 | 0.0008 | 0.0008 | 0.0008 | 0.0007 | 0.0006 | 0.0004 |
| None | 0.1662 | 0.2309 | 0.2673 | 0.4324 | 0.3836 | 0.0868 | 0.1579 | 0.1438 | 0.1593 | 0.1614 | 0.1636 | 0.0903 | 0.2099 | 0.1924 | 0.1845 | 0.2804 | 0.2354 | 0.137 |
| Nuclear Periphery | 0.0386 | 0.0361 | 0.0249 | 0.022 | 0.0382 | 0.0384 | 0.0477 | 0.03 | 0.0313 | 0.0188 | 0.016 | 0.0157 | 0.0296 | 0.016 | 0.0273 | 0.011 | 0.0112 | 0.0122 |
| Nucleolus | 0.0039 | 0.0059 | 0.0075 | 0.0057 | 0.0011 | 0.0061 | 0.0059 | 0.0038 | 0.0054 | 0.0052 | 0.0117 | 0.0064 | 0.0048 | 0.0039 | 0.0064 | 0.0077 | 0.0055 | 0.0093 |
| Nucleus | 0.3017 | 0.3943 | 0.3463 | 0.1765 | 0.2157 | 0.5912 | 0.4215 | 0.4957 | 0.5509 | 0.5737 | 0.4575 | 0.6295 | 0.558 | 0.6176 | 0.6159 | 0.5645 | 0.5374 | 0.6693 |
| Peroxisomes | 0.0076 | 0.0003 | 0.0191 | 0.0199 | 0.0049 | 0.0005 | 0.0186 | 0.0001 | 0.0076 | 0.0035 | 0.0101 | 0.004 | 0.0003 | 0.0039 | 0.0002 | 0.0001 | 0.0003 | 0.0002 |
| Punctate Nuclear | 0.0554 | 0.0389 | 0.0537 | 0.0607 | 0.0321 | 0.046 | 0.0289 | 0.0364 | 0.027 | 0.0453 | 0.0282 | 0.0549 | 0.0417 | 0.0252 | 0.0462 | 0.0577 | 0.0901 | 0.0615 |
| Vacuole | 0.0121 | 0.0049 | 0.007 | 0.0013 | 0.0017 | 0.0055 | 0.0068 | 0.0035 | 0.0024 | 0.0012 | 0.006 | 0.0022 | 0.0033 | 0.0029 | 0.0015 | 0.0005 | 0.0007 | 0.0008 |
| Vacuole Periphery | 0.0074 | 0.0008 | 0.0013 | 0.0007 | 0.0006 | 0.002 | 0.0025 | 0.0006 | 0.0009 | 0.0003 | 0.0011 | 0.0005 | 0.0007 | 0.0003 | 0.0004 | 0.0002 | 0.0002 | 0.0002 |
Sequencing Data
| R1 | R2 | |||||||||
|---|---|---|---|---|---|---|---|---|---|---|
| G1 Post-START | S/G2 | Metaphase | Anaphase | Telophase | G1 Post-START | S/G2 | Metaphase | Anaphase | Telophase | |
| Gene Expression | 9.1349 | 6.0171 | 4.465 | 9.33 | 6.2336 | 2.8831 | 6.0839 | 9.5323 | 6.4302 | 10.6078 |
| Translational Efficiency | – | – | – | – | – | – | – | – | – | – |
Hit Data
| Dataset | Hit |
|---|---|
| Protein Concentration | ✘ |
| Protein Localization | ✘ |
| Gene Expression | ✘ |
| Translational Efficiency | – |
Endocytosis
| Temp | Actin Patch (Sac6-tdTomato) | Cortical Patch (Sla1-GFP) | Late Endosome (Snf7-GFP) | Vacuole (Vph1-GFP) |
|---|---|---|---|---|
| 37℃ | ||||
| RT |
Cell Cycle Omics
CYCLoPs (Dpb11-GFP)
| Gene / Allele | Actin Patch (Sac6-tdTomato) | Cortical Patch (Sla1-GFP) | Late Endosome (Snf7-GFP) | Vacuole (Sac6-tdTomato) |
|---|
| Gene | Images |
|---|
| Gene | Images |
|---|
Images are not yet available
Images are not yet available